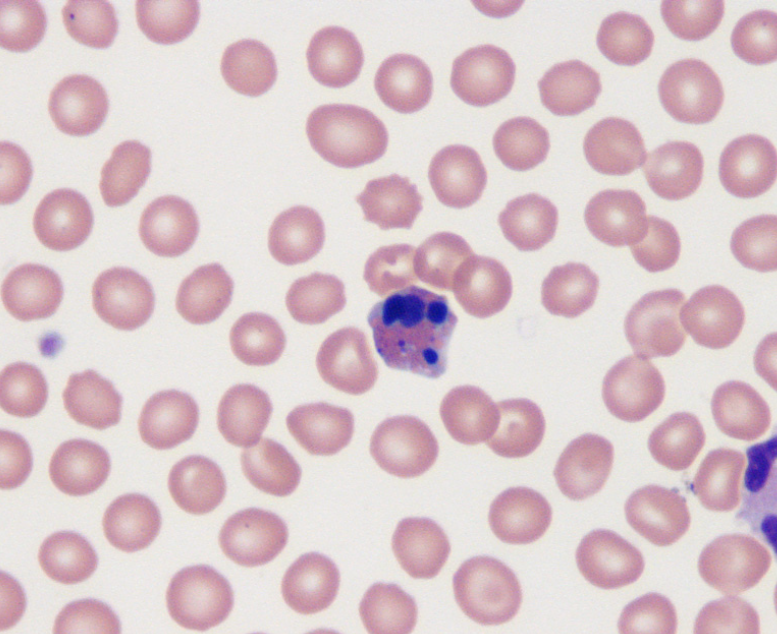
term image
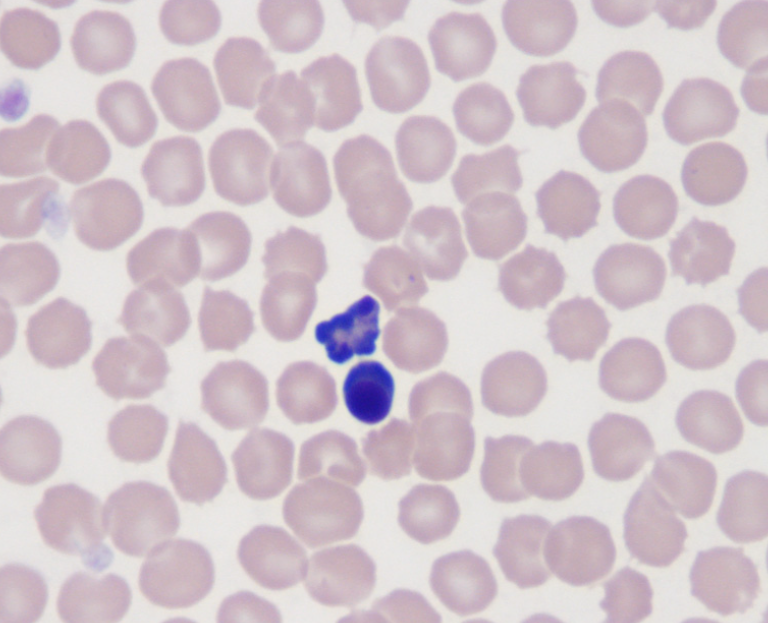
term image
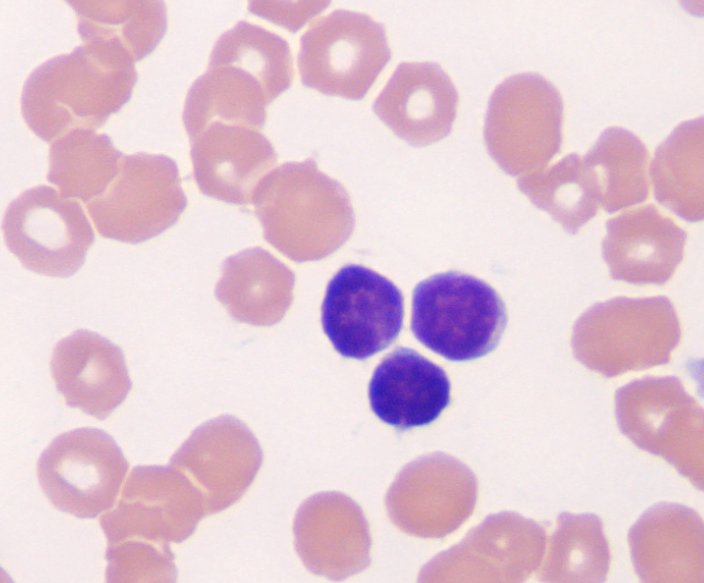
term image
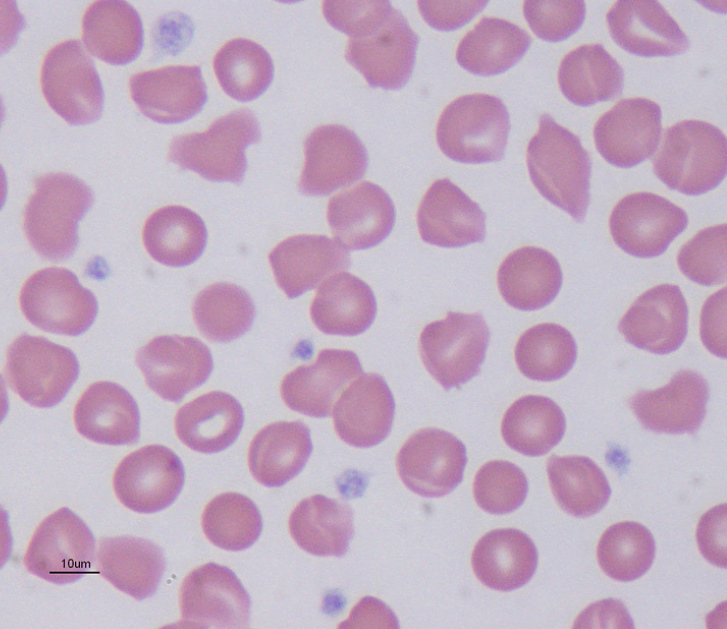
term image
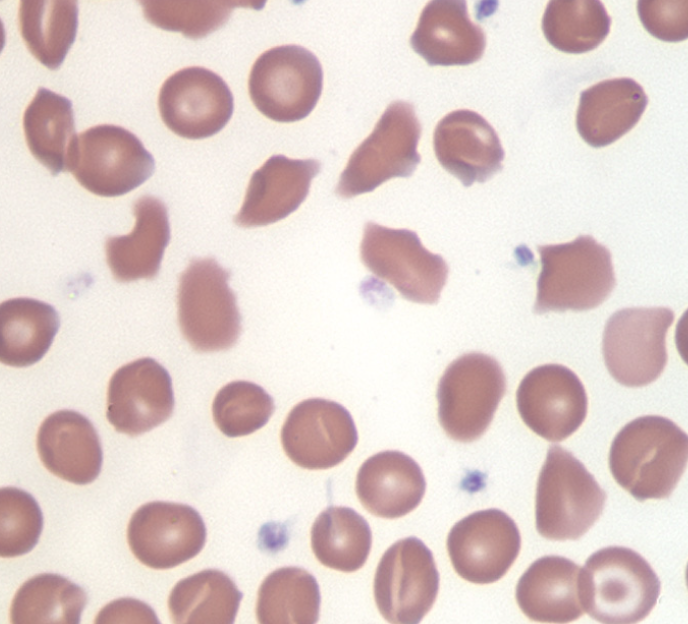
term image
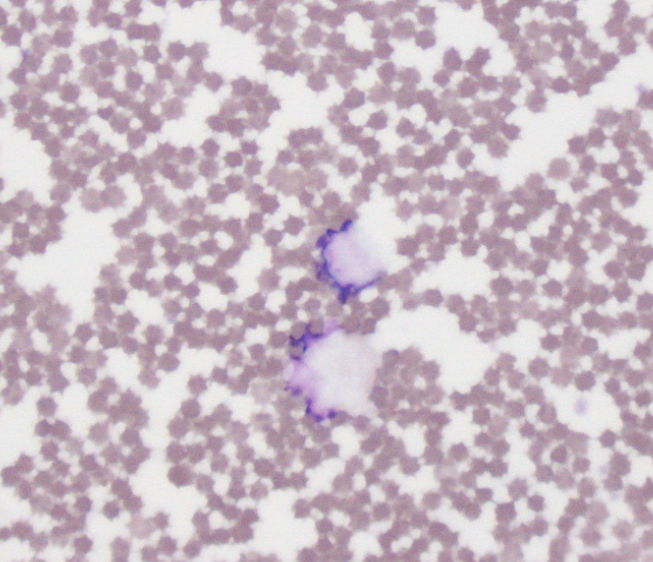
term image
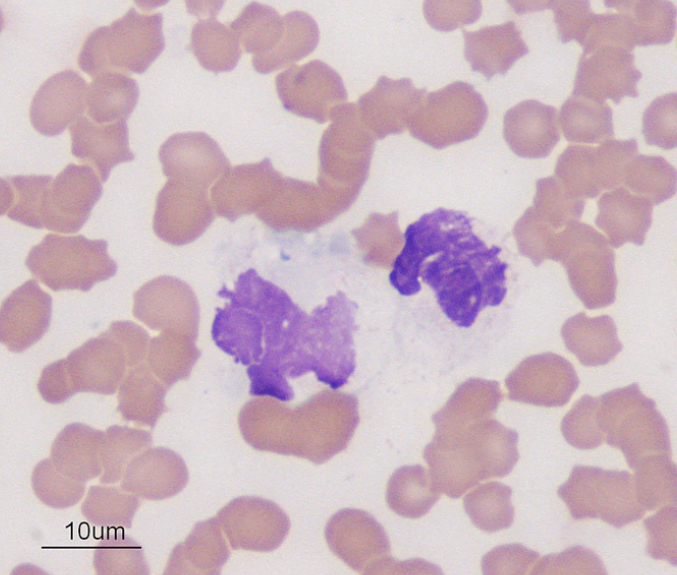
term image
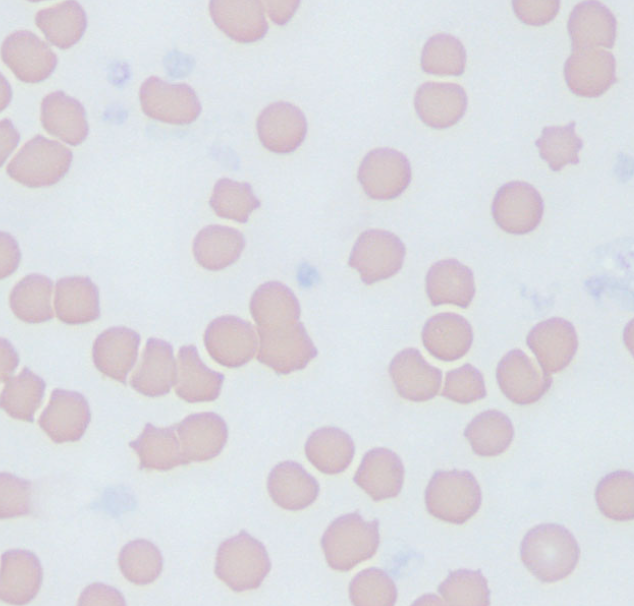
term image
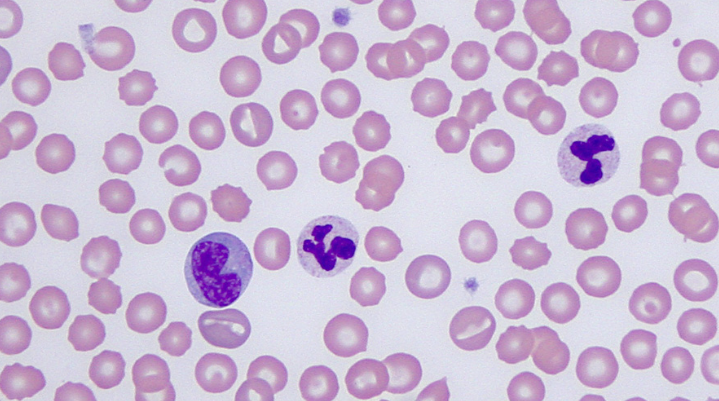
term image
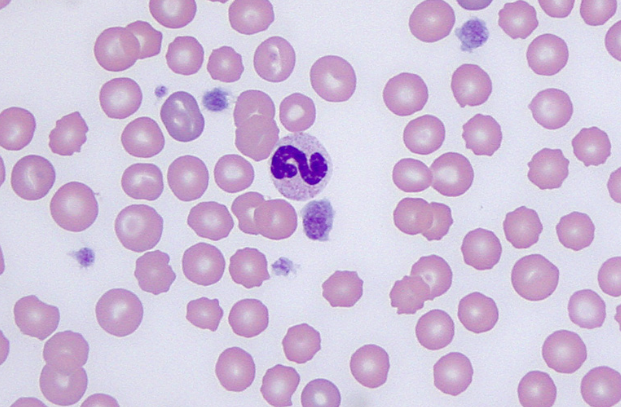
term image
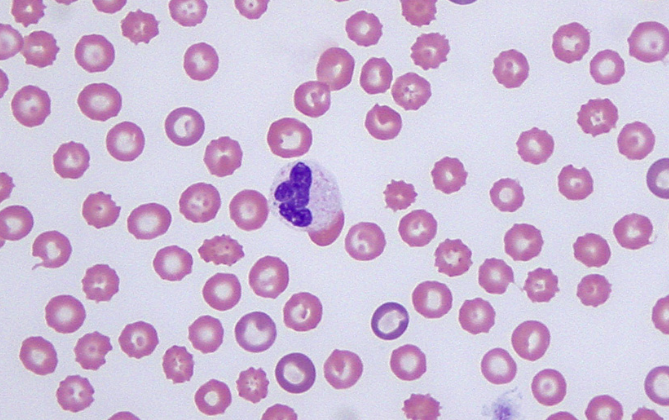
term image
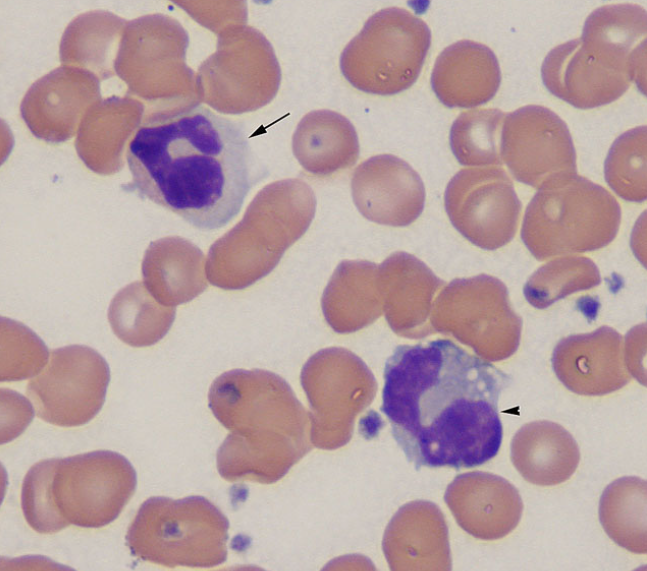
term image
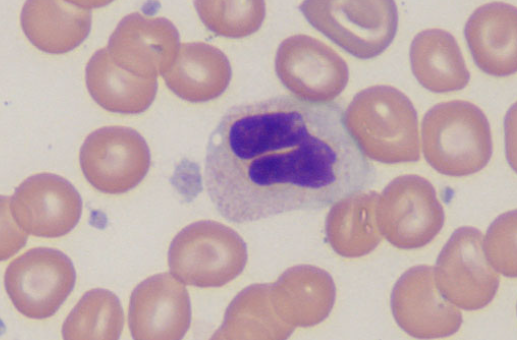
term image
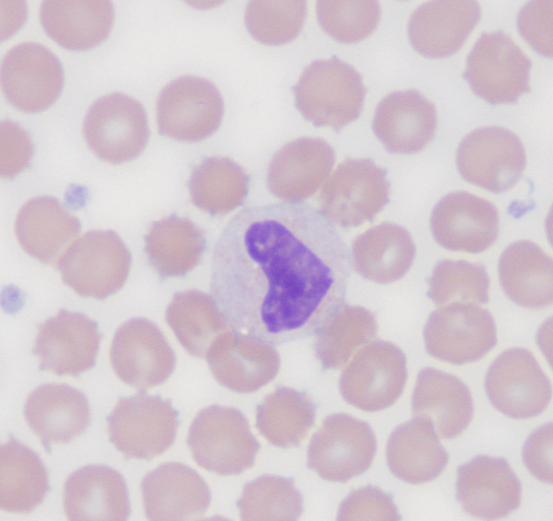
term image
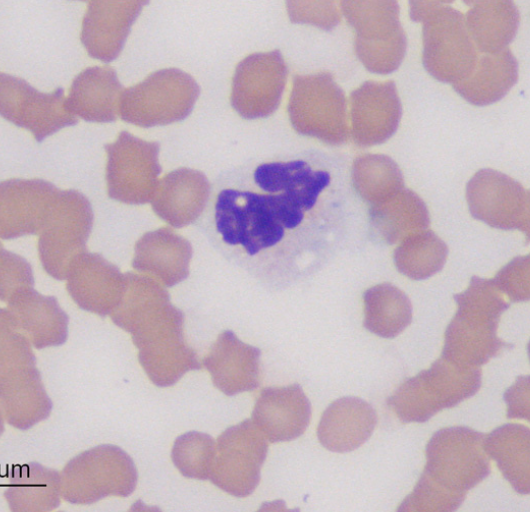
<p>blue in cytoplasm&nbsp;</p>

1/31
Looks like no tags are added yet.
Name | Mastery | Learn | Test | Matching | Spaced |
|---|
No study sessions yet.
apoptotic eosinophil (WBC)
DOG
apoptotic wbc
horse
WBC clumping

hemolyzed rbc
storage-associated change
lipemia (RBC)
Lipemia (RBC)
smudged cells
Echinocytic RBCs
cow

smudged cells
Echinocytic RBCs
cow
basket cells
smudged cells in equine blood
platelet
cat

platelet clump
horse

platelet clump
cow

endothelial cells
monocyte on left
2 neutrophils
S-band neutrophil
immature but non toxic
neutrophils

monocyte

neutrophil
a medical finding that indicates an increase in immature, or "baby," neutrophils in the bloodstream, often caused by the bone marrow releasing them early to fight infection or inflammation. This is a sign that the body's demand for neutrophils is high, outpacing the supply of mature cells, and can signify an active infection or inflammatory process.
left shift

false band neutrophil

arrowhead
echinocyte
false band neutrophil
cytoplasmic granule (neutrophil)
false metamyelocyte

arrow: platelet clump
aged neutrophil
horse

rbc
echinocytes
blue in cytoplasm
dohle bodies
neutrophils
horse

wbc
apoptotic wbc
horse

rbc
echinocytes rbc
horse

stain precipitate
rbc are echinocytes (horse)

bacterial contamination